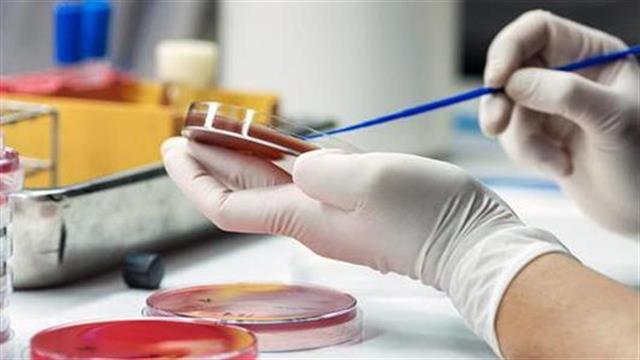
ΕΜΑ: Προς περιορισμό της γραφειοκρατίας στις κλινικές μελέτες για ανάπτυξη νέων αντιβιοτικών

Το πλαίσιο αξιολόγησης νέων αντιβιοτικών, τα οποία προορίζονται για την αντιμετώπιση βακτηριακών λοιμώξεων αναθεωρεί ο Ευρωπαϊκός Οργανισμός Φαρμάκων (ΕΜΑ).
Οι υπεύθυνοι του Οργανισμού έχουν εκδώσει μία σειρά από κατευθυντήριες γραμμές, οι οποίες έχουν τεθεί σε εξάμηνη διαβούλευση με τους αρμόδιους φορείς έως την 31 Ιουλίου.
Τα ενδιαφερόμενα μέρη μπορούν να στείλουν τις παρατηρήσεις τους στη διεύθυνση που αναγράφεται στον σχετικό σύνδεσμο του ΕΜΑ.
Με τον τρόπο αυτό, ο Ευρωπαϊκός Οργανισμός Φαρμάκων αναδεικνύει τον σημαντικό ρόλο στην καταπολέμηση της αντιμικροβιακής αντοχής.
Υποστηρίζει την ανάπτυξη νέων φαρμάκων και προσεγγίσεων θεραπείας, ειδικά για ασθενείς με λοιμώξεις που προκαλούνται από βακτήρια ανθεκτικά σε πολλαπλά φάρμακα και έχουν περιορισμένες θεραπευτικές επιλογές.
Η αντιμικροβιακή αντοχή είναι ένα παγκόσμιο πρόβλημα δημόσιας υγείας. Οι ρυθμιστικές αρχές της Ευρωπαϊκής Ένωσης, των ΗΠΑ και της Ιαπωνίας προσπαθούν να συμφωνήσουν στον κοινό σχεδιασμό των κλινικών δοκιμών.
Η παρούσα πρόταση αναθεώρησης του ισχύοντος πλαισίου, στοχεύει στην εναρμόνιση του καθεστώτος που ισχύει στις χώρες αυτές.
Παρέχει, επίσης, διευκρινίσεις σχετικά με την κλινική ανάπτυξη αντιβακτηριακών παραγόντων που αναμένεται να αντιμετωπίσουν μία ακάλυπτη ιατρική ανάγκη, σύμφωνα με την πείρα που αποκτήθηκε από προηγούμενες ρυθμιστικές αποφάσεις.
Στα κείμενα του ΕΜΑ έχουν προστεθεί ειδικές συμβουλές σχετικά με τις κανονιστικές απαιτήσεις της Ευρωπαϊκής Ένωσης για την ανάπτυξη φαρμάκων για τη θεραπεία ανεπιθύμητων λοιμώξεων του ουροποιητικού συστήματος και γονόρροιας.
Το σχέδιο αναθεωρημένης κατευθυντήριας γραμμής εγκρίθηκε από την επιτροπή ανθρωπίνων φαρμάκων του ΕΜΑ (CHMP).
Οπλοστάσιο
Σύμφωνα με τους επιστήμονες, το επιστημονικό “οπλοστάσιο” κατά των λοιμώξεων έχει περιοριστεί.
Νέα πολυανθεκτικά ή πανανθεκτικά μικρόβια αντιμετωπίζονται με ελάχιστα ή κανένα από τα υπάρχοντα αντιοβιοτικά.
Η αύξηση της ανθεκτικότητάς τους είναι δυσανάλογη με την κυκλοφορία νέων αντιβιοτικών, με αποτέλεσμα η κατάσταση να οδηγείται παγκοσμίως σε οριακό σημείο.
Η μικροβιακή αντοχή αποτελεί μία διαχρονική και συνεχώς εξελισσόμενη κρίση Δημόσιας Υγείας, τόσο στις αναπτυσσόμενες όσο και στις ανεπτυγμένες χώρες.
Ανθεκτικά
Σε αρκετές χώρες, μεταξύ των οποίων και η Ελλάδα, ασθενείς εμφανίζουν λοιμώξεις από βακτήρια ανθεκτικά σε όλα σχεδόν τα διαθέσιμα αντιβιοτικά.
Ανθεκτικά βακτήρια στα τελευταία διαθέσιμα αντιβιοτικά για τη θεραπεία απειλητικών για τη ζωή λοιμώξεων έχουν επιμολύνει το περιβάλλον και τα ζώα και μπορούν να μεταδοθούν στον άνθρωπο μέσω της επαφής ή μέσω της τροφικής αλυσίδας.
Στο πλαίσιο αυτό, το ευρωπαϊκό (ECDC) και το ελληνικό Κέντρο Ελέγχου και Πρόληψης Νοσημάτων (ΚΕΕΛΠΝΟ) πραγματοποιούν εθνικές εκστρατείες για την προώθηση της ορθολογικής χρήσης των αντιβιοτικών στην κοινότητα και στον νοσοκομειακό χώρο.
Τα αντιβιοτικά είναι πολύτιμα φάρμακα και η διαφύλαξη της αποτελεσματικότητάς τους μας αφορά όλους. Για αυτόν τον λόγο, η προσπάθεια ευαισθητοποίησης αφορά τόσο στους επαγγελματίες Υγείας που συνταγογραφούν τα αντιβιοτικά, όσο και τους πολίτες που τα καταναλώνουν.
Προσθέστε το iatronet.gr στο DiscoverΕιδήσεις υγείας σήμερα
Φάρμακο: Όταν ο λογαριασμός αποκαλύπτει τις αδυναμίες του συστήματος
Διασφάλιση βιωσιμότητας των Συλλόγων ασθενών
Το EAES 2026 φέρνει στην Αθήνα την παγκόσμια ελίτ της ενδοσκοπικής χειρουργικής
Ασφαλιστικές: Γιατί ''ανεβαίνουν'' τα ασφάλιστρα
Ασφαλιστικές: Γιατί ''ανεβαίνουν'' τα ασφάλιστρα Νέο Διοικητικό Συμβούλιο στον Πανελλήνιο Σύλλογο Επισκεπτών Υγείας
Νέο Διοικητικό Συμβούλιο στον Πανελλήνιο Σύλλογο Επισκεπτών Υγείας ΕΟΦ: Απαγόρευση διάθεσης τροφίμου - Τι βρέθηκε στους ελέγχους
ΕΟΦ: Απαγόρευση διάθεσης τροφίμου - Τι βρέθηκε στους ελέγχους Η 1η ΥΠΕ Αττικής και το ''Άλμα Ζωής'' ενώνουν δυνάμεις για ένα ασθενοκεντρικό Δίκτυο Κέντρων Μαστού
Η 1η ΥΠΕ Αττικής και το ''Άλμα Ζωής'' ενώνουν δυνάμεις για ένα ασθενοκεντρικό Δίκτυο Κέντρων Μαστού Υπουργείο Υγείας: Παραλαβή 10 αυτόματων εξωτερικών απινιδωτών, δωρεά της εταιρίας ''Stoiximan''
Υπουργείο Υγείας: Παραλαβή 10 αυτόματων εξωτερικών απινιδωτών, δωρεά της εταιρίας ''Stoiximan'' Ισχυρή πρωτιά της ΔΗΚΙ στις εκλογές του Ιατρικού Συλλόγου Αθηνών - Ρεκόρ συμμετοχής
Ισχυρή πρωτιά της ΔΗΚΙ στις εκλογές του Ιατρικού Συλλόγου Αθηνών - Ρεκόρ συμμετοχής Φάρμακο: Όταν ο λογαριασμός αποκαλύπτει τις αδυναμίες του συστήματος
Φάρμακο: Όταν ο λογαριασμός αποκαλύπτει τις αδυναμίες του συστήματος Καλοκαιρινές αλλεργίες: Όσα πρέπει να γνωρίζετε
Καλοκαιρινές αλλεργίες: Όσα πρέπει να γνωρίζετε![Οι απρόσμενες συνέπειες της ολοκληρωτικής παράλειψης της ζάχαρης από τη διατροφή [μελέτη]](/media/articles/photos/thumb/140911-137753130059sugar.jpg) Οι απρόσμενες συνέπειες της ολοκληρωτικής παράλειψης της ζάχαρης από τη διατροφή [μελέτη]
Οι απρόσμενες συνέπειες της ολοκληρωτικής παράλειψης της ζάχαρης από τη διατροφή [μελέτη] Τα αναψυκτικά με ασπαρτάμη είναι λιγότερο επικίνδυνα για καρκίνο του ήπατος από τα ζαχαρούχα
Τα αναψυκτικά με ασπαρτάμη είναι λιγότερο επικίνδυνα για καρκίνο του ήπατος από τα ζαχαρούχα Θεσσαλονίκη: Αγώνας ζωής για ένα μικρό θαύμα 470 γραμμαρίων
Θεσσαλονίκη: Αγώνας ζωής για ένα μικρό θαύμα 470 γραμμαρίων Καρπούζι: Ποια είναι τα οφέλη του στην υγεία
Καρπούζι: Ποια είναι τα οφέλη του στην υγεία 9 εξακριβωμένα οφέλη του κολοκυθόσπορου
9 εξακριβωμένα οφέλη του κολοκυθόσπορου ΔΕΠΥ: Πώς εμφανίζεται στις γυναίκες και γιατί συχνά αργεί η αναγνώριση
ΔΕΠΥ: Πώς εμφανίζεται στις γυναίκες και γιατί συχνά αργεί η αναγνώριση Εμ. Ροηλίδης: Διεθνής διάκριση για τον καθηγητή Παιδιατρικής λοιμωξιολογίας
Εμ. Ροηλίδης: Διεθνής διάκριση για τον καθηγητή Παιδιατρικής λοιμωξιολογίας Δάκτυλος Τραμπ απειλεί τις τιμές των φαρμάκων στην Ελλάδα
Δάκτυλος Τραμπ απειλεί τις τιμές των φαρμάκων στην Ελλάδα Κακοσμία του στόματος: Τι προβλήματα μπορεί να δείχνει
Κακοσμία του στόματος: Τι προβλήματα μπορεί να δείχνει